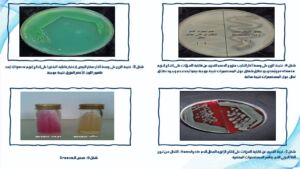
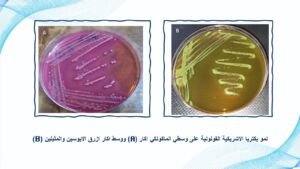

29 ديسمبر، 2024
اطروحة دكتوراه تناقش دراسة مظهرية وجزيئية لعوامل ضراوة الإشريكية القولونية

نوقشت في قسم علوم الحياة بكلية العلوم / جامعة الموصل اطروحة الدكتوراه الموسومة ” دراسة مظهرية وجزيئية لعوامل ضراوة الإشريكية القولونية المعزولة من الفلورا الطبيعية والمصادر السريرية في الإنسان ” يوم الأحد الموافق 29 كانون الأول 2024 ترأست لجنة مناقشتها السيدة عميد الكلية الأستاذ الدكتورة هيام عادل إبراهيم المحترمة و حضر جانباً منها السادة معاونا العميد للشؤون العلمية والإدارية والسيد رئيس القسم وعدد من تدريسيي الكلية المحترمين .
تناولت الاطروحة التي تقدمت بها الطالبة (رنى وعدالله يونس عبدالله) تقييم خطورة بكتريا الفلورا الطبيعية Escherichia coli مقارنة بعزلاتها المرضية ، حيث عزلت هذه البكتريا من الفلورا الطبيعية لأمعاء الأطفال حديثي الولادة والبالغين الأصحاء ومن العينات المرضية وشخصت مظهرياً بجهاز الفايتك وجزيئياً باعتماد الجين 16SRNA .واجري لها التسلسل الجيني .
تم التحري أيضاً عن أنماط حساسيتها تجاه المضادات الحيوية فضلاً عن الكشف المظهري عن عوامل ضراوتها المختلفة ومحتواها البلازميدي ، كذلك الكشف المظهري عن قابلية الالتصاق على الخلايا الظهارية البولية ، والكشف عن امتلاكها لجين الالتصاق الاساسي fim H .
تم التطرق إلى دراسة قابلية المستخلصات المائية والكحولية لكل من الشاي الأسود والأخضر والقهوة السوداء والخضراء وبروتين الحليب البشري اللاكتوفرين المستخلص في الدراسة الحالية على تثبيط الالتصاق في العزلات المدروسة مظهرياً على الخلايا الظهارية البولية وجزيئياً على مستوى التعبير الجيني للجين fim H. وأثبتت الدراسة خطورة بكتريا الفلورا الطبيعية Escherichia coli من الناحية الإمراضية وقدرة مواد التثبيط المدروسة على تثبيط الالتصاق مظهرياً وجزيئياً.
ترأس لجنة المناقشة السيدة عميد الكلية الأستاذ الدكتورة هيام عادل إبراهيم وعضوية كل من الأستاذ المساعد الدكتور شاكر غازي جرجيس و الأستاذ المساعد الدكتور أنمار أحمد داؤود و الأستاذ المساعد الدكتورة منال صالح مهدي و الأستاذ المساعد الدكتورة بشرى دلي حمد وبإشراف وعضوية الأستاذ الدكتور محسن أيوب عيسى.
قدّمت السيدة عميد الكلية كتاب شكر وتقدير للأستاذ المساعد الدكتورة منال صالح مهدي من كلية الزراعة / جامعة تكريت ؛ لتكبدها عناء السفر ومشاركتها في لجنة المناقشة.
تمنياتنا لجميع أساتذتنا وطلبتنا الأعزاء دوام الموفقية والنجاح والتألق العلمي.
شعبة الإعلام والاتصال الحكومي
الأحد 29 كانون الأول 2024